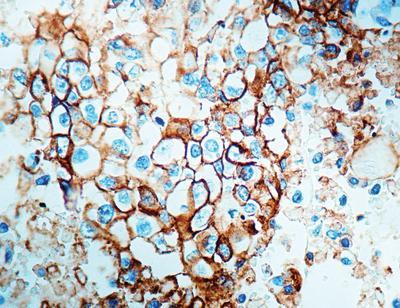

Epithelial Antigen Conc. Mab ,Each
$ 711.32
|
|
Details:
Epithelial Antigen^ Clone number VU-1D9, This antibody reacts with two glycoproteins of 34 and 49 kD present on the epithelial cells. It stains with simple epithelia and basal layers of stratified non-keratinized squamous epithelium.
Additional Information
| SKU | 2321001 |
|---|---|
| UOM | EACH |
| UNSPSC | 12352203 |
| Manufacturer Part Number | MOB 062 |
| Product Dimensions | 8X5X4 Inches |
| Product Weight | 1 |
